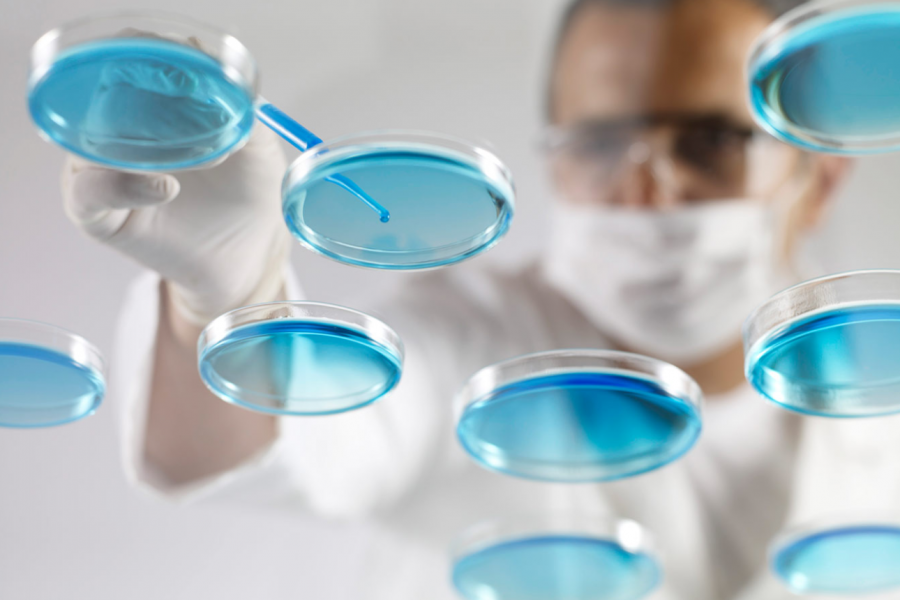

Kiadis Pharma secures €20m debt financing facility from Kreos Capital

Kiadis Pharma N.V. ("Kiadis Pharma" or the "Company") (Euronext Amsterdam and Brussels:KDS), a clinical stage…
Ben (Reactive)01/08/2018